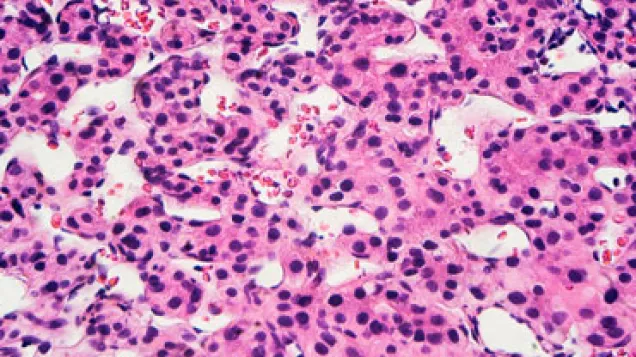
Hepatitis virus particles, TEM. © Science Photo Library

World Hepatitis Day 2015
World Hepatitis Day is marked on 28 July each year to increase the awareness and understanding of viral hepatitis. The five known hepatitis viruses are types A, B, C, D and E. ECDC coordinates the enhanced surveillance for hepatitis A (HAV), B (HBV) and C (HCV).
Viral hepatitis affects millions of people across Europe but as many infections are accompanied by no symptoms, the ‘silent disease’ is often not diagnosed. Left untreated, chronic infection with hepatitis B and C may progress to liver cirrhosis or cancer.
On the occasion of World Hepatitis Day 2015, ECDC launched the analysis of the 2013 surveillance data on hepatitis B and C in the EU/EEA showing that the rate of reported hepatitis C was more than twice as high as that for hepatitis B across the EU and diagnosed chronic infections dominate for both diseases.
Between 2006 and 2013, more than 137 000 newly diagnosed cases of hepatitis B and over 241 000 newly diagnosed hepatitis C infections were reported in the EU/EEA. But this is known to be an underestimate of the true burden as hepatitis is largely asymptomatic and the ‘silent disease’ is often not diagnosed.
Food-borne transmission of hepatitis A virus has been implicated in several outbreaks in recent years: between 2007 and 2012, ECDC and EFSA reported and assessed 14 outbreaks with strong evidence of hepatitis A as the cause. The food items were imported from areas where the virus is still circulating, both outside and inside the EU/EEA. In 2014, hepatitis A was recognised as a re-emerging threat, with travels to endemic areas and consumption of contaminated food items as the main risk factors in Europe.
Infected but unaware
Around 4.5 million people are estimated to suffer from infection with hepatitis B and some 5.5 million from hepatitis C infection in the EU – and the majority of these individuals are unaware of their infection. Untreated chronic hepatitis B and C infections may lead to liver cirrhosis or cancer.
Reaching and testing those at risk of infection is still a public health challenge across Europe which is why ECDC supports the efforts of the European HIV-Hepatitis Testing Week that now includes testing for hepatitis.
The aim of World Hepatitis Day marked on 28 July each year, is to increase the awareness and understanding of viral hepatitis and the five known hepatitis viruses, referred to as types A, B, C, D and E.
Testing saves lives
-
A quick blood test helps to check if you have hepatitis.
-
Viral hepatitis is preventable and curable.
-
Vaccination is the most effective individual measure to protect yourself against hepatitis A and B. And hepatitis C can be cured, especially if it is detected and treated early.
ECDC coordinates the enhanced surveillance for hepatitis A, B and C to help EU countries assess the hepatitis disease burden, evaluate existing prevention and control strategies, and to define epidemiological trends or transmission patterns.
Related content
Share this page